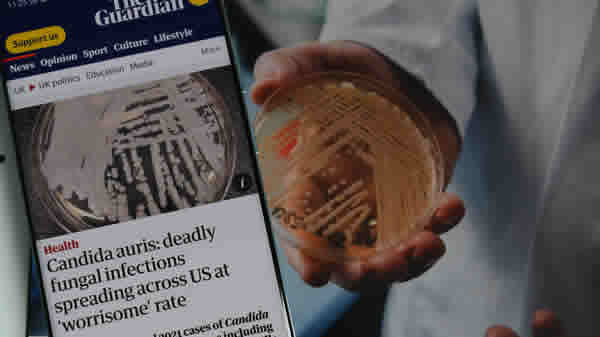

Candida auris: brasileiros infectados por superfungo seguem internados; entenda
Microrganismo é motivo de alerta para autoridades de saúde; expectativa de vida pode chegar a 90 dias
O terceiro caso de infecção pelo superfungo Candida auris foi confirmado no Brasil. Trata-se do terceiro caso confirmado no país, todos registrados no estado de Pernambuco.
O terceiro caso de infecção pelo superfungo Candida auris foi confirmado no Brasil. Trata-se do terceiro caso confirmado no país, todos registrados no estado de Pernambuco.
O paciente é um homem de 66 anos e está internado em um hospital particular de Recife. Segundo a Secretaria de Saúde do Estado de Pernambuco, outros dois homens já haviam sido diagnosticados com o fungo neste mês e estão internados em hospitais da rede pública.
Um deles tem 48 anos e está internado no Hospital Miguel Arraes em Paulista. Após o diagnóstico, no dia 11 de maio, a unidade de saúde suspendeu o atendimento do público em geral e só atendeu casos de urgência e emergência.
O segundo paciente tem 77 anos está no Hospital do Tricentenário que fica em Olinda e suspendeu o atendimento apenas no setor onde o paciente está.
A Secretaria investiga se as três pessoas foram infectadas nas unidades hospitalares ou em outro ambiente. E está testando as pessoas que tiveram contato com os pacientes para saber se foram infectadas.
A situação preocupa as autoridades sanitárias porque estudo da Fiocruz afirma que Pernambuco possui o maior surto desse superfungo registrado no Brasil.
Foram 48 casos da doença identificados entre novembro de 2021 e fevereiro de 2022 em Recife.
De acordo com o Ministério da Saúde, o Candida auris foi identificado pela primeira vez como causador de doença em humanos em 2009 no Japão.
Desde então, ele vem se espalhando pelo mundo e passou a ser identificado como superfungo por ser resistente a praticamente todos os medicamentos produzidos.
De fácil contágio, ele pode ser transmitido por materiais hospitalares como medidores de pressão, macas, termômetros e estetoscópios. Além disso, é de difícil diagnóstico e tem alta taxa de letalidade, onde de 30 a 60% dos contaminados morrem.
Candida auris: um fungo preocupante que desafia os sistemas de saúde
Um fungo resistente e mortal tem gerado preocupação no cenário da saúde global. A Candida auris, descoberta no Japão em 2009, tem se espalhado pelo mundo, afetando especialmente pessoas com sistemas imunológicos debilitados e causando infecções graves em ambientes hospitalares. Sua origem exata ainda é pouco conhecida, mas pesquisadores atribuem seu surgimento e disseminação às mudanças climáticas e ao aquecimento global.
A transmissão do fungo ainda não é completamente compreendida, mas evidências iniciais sugerem que ele se espalha por meio do contato com superfícies ou equipamentos contaminados em quartos de pacientes colonizados ou infectados. Diante disso, é fundamental reforçar as medidas de prevenção e controle, como a higiene das mãos, a limpeza e a desinfecção adequada do ambiente e dos equipamentos em serviços de saúde.
Nesta quinta-feira, a Secretaria de Saúde de Pernambuco anunciou a criação de um comitê estadual de enfrentamento à Candida auris. Composto por especialistas de diversas áreas, desde epidemiologistas até biomédicos, o objetivo é promover discussões que contribuam para a prevenção de novos casos no estado. A SES-PE ressaltou a importância da vigilância para aqueles que tiveram contato com pacientes infectados, a fim de monitorar qualquer possível disseminação do fungo.
Em relação à letalidade, o Centro de Controle e Prevenção de Doenças (CDC) dos Estados Unidos aponta que quase metade dos pacientes infectados com Candida auris morrem em um prazo de 90 dias. No entanto, é importante ressaltar que muitos dos afetados já possuem outros problemas de saúde, pois geralmente estão internados por motivos diversos. A gravidade do quadro se agrava quando associada a outras condições debilitantes.
A disseminação da Candida auris é um alerta para a necessidade de fortalecer os protocolos de prevenção e controle de infecções nos serviços de saúde em todo o mundo. A pesquisa contínua e a colaboração entre especialistas são cruciais para entender melhor esse fungo e desenvolver estratégias eficazes para combatê-lo. Acompanhar as diretrizes e recomendações das autoridades de saúde é fundamental para garantir a segurança dos pacientes e evitar a propagação desse fungo resistente e letal.
Fonte: Agência Brasil














